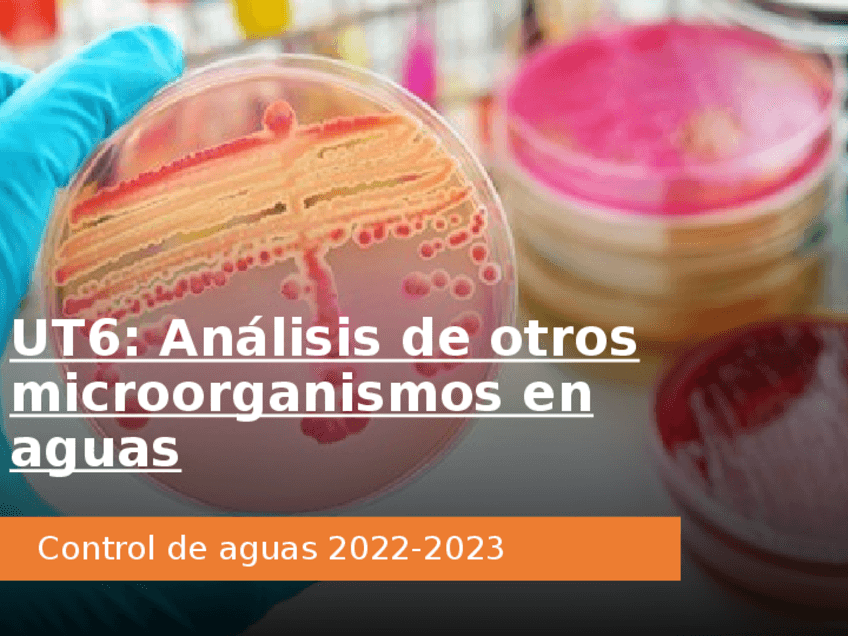

UT1-agua.pptx

UT2-Disoluciones-diluciones-medida-y-reactivos.pptx

UT3-Origenes-del-agua-para-consumo-alumnos-en-pwp-si.pptx

Material-de-laboratorio-para-examen-visu-con-numeros.pptx

UT4-Laboratorio-de-analisis-microbiologico-pwp-alumnos.pptx

UT5-Analisis-de-bacterias-en-aguas-en-pwp-alumno.pptx
UT6-Analisis-de-otros-microorganimos-en-aguas-en-pwp-alumnos.pptx

UT8-Enfermedades-de-transmision-hidrica-alumnos.pptx

UT7-Analisis-microbiologico-de-aguas-de-consumo-en-pwp-alumnos.pptx

UT9-Contaminacion-de-las-aguas-alumnos-en-pwp.pptx

UT12-Sistemas-de-abastecimiento-y-envasado-de-agua-pwp-alumno.pptx

UT13-Tratamientos-aguas-ETAP-pwp-alumno.pptx

UT14-Tratamientos-aguas-ETAP-pwp-alumno.pptx

UT15-1a-parte-Teoria-pH-y-pHmetro-pwp-para-practica-21.pptx

UT15-2a-parte-Teoria-valoraciones-para-practica-22-pwp.pptx

UT15-3a-parte-Teoria-de-soluciones-tampon-para-practica-25-pwp.pptx

UT16-1a-parte-Teoria-conductimetro-para-practica-24-pwp.pptx

UT16-2a-parte-Teoria-Cromatografia-para-practica-26-pwp.pptx

UT16-3a-parte-Teoria-de-espectrofotometria-para-practica-23-pwp.pptx
